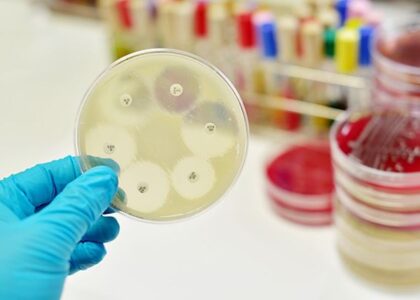
Antimicrobial Packaging Market

Antimicrobial Packaging Market is projected to accumulate a valuation of US$ 20.1 billion with CAGR of 5.7% by 2033
The global antimicrobial packaging market is predicted to reach a market value of US$ 11.5 billion in


The global antimicrobial packaging market is predicted to reach a market value of US$ 11.5 billion in
As per the comprehensive analysis conducted by ESOMAR-certified consulting firm, FMI, the global Antimicrobial Packaging Market is